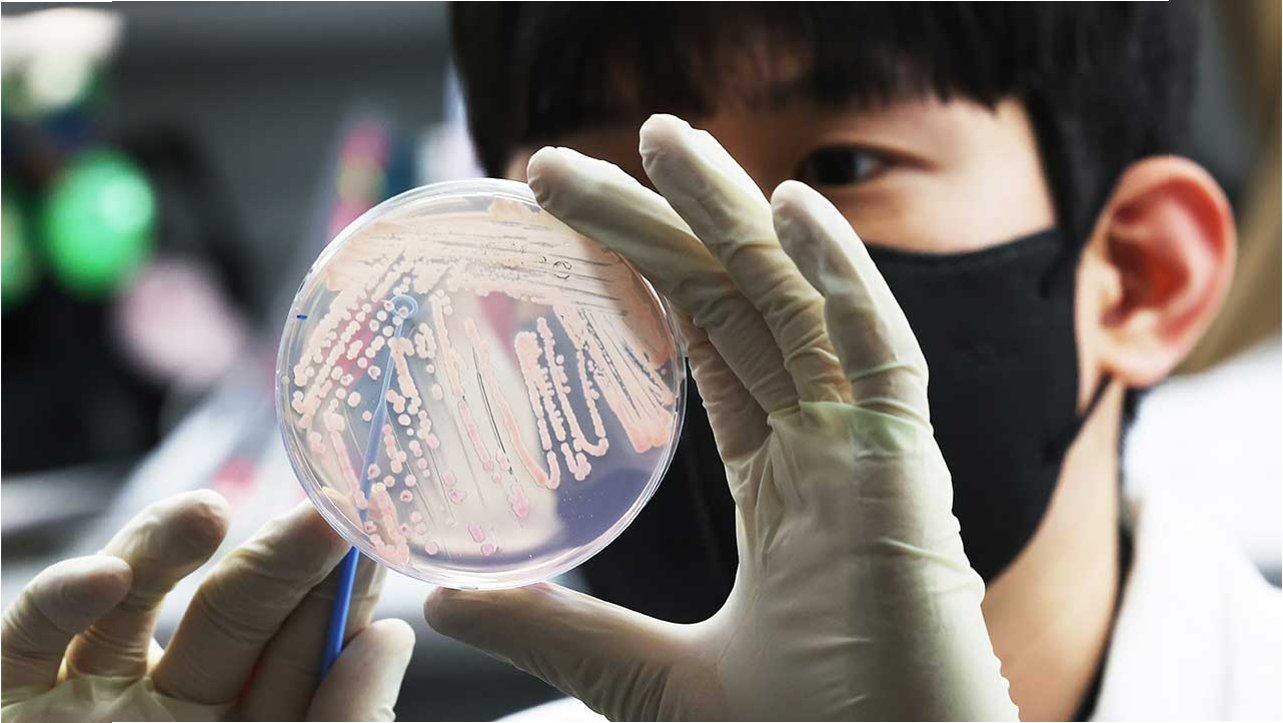

산나물 섭취 후 발생한 식중독 사고
최근 경북 영양군에서 산나물을 넣어 끓인 라면을 먹은 주민 6명이 식중독 증세를 보여 병원 치료를 받는 안타까운 사고가 발생했습니다. 이들은 40대에서 60대 사이의 이웃 주민들로, 한 집에서 함께 식사한 후 어지럼증, 구토, 마비 증상을 호소했습니다. 생명에는 지장이 없으나, 산나물 섭취의 위험성을 다시 한번 일깨워주는 사건입니다.

사고 원인, 전호나물에 대한 조사
조사 결과, 주민들은 울릉도가 주산지인 '전호나물'을 함께 나눠 먹은 것으로 확인되었습니다. 전호나물 자체는 식용이 가능한 나물이지만, 이번 사고와 관련하여 독초나 다른 유해 물질이 섞여 있었는지 여부에 대해 보건 당국이 정밀 역학 조사를 진행 중입니다. 정확한 사고 경위 파악을 위해 관련 검사와 조사가 필수적입니다.
식중독 예방을 위한 산나물 섭취 시 주의사항
산나물은 봄철 별미로 많은 사랑을 받지만, 야생에서 채취하거나 출처가 불분명한 산나물은 독초와 혼동될 위험이 있습니다. 따라서 산나물을 섭취할 때는 반드시 식용 가능한 나물인지 정확히 확인하고, 신뢰할 수 있는 곳에서 구매하거나 채취해야 합니다. 또한, 조리 전에는 깨끗하게 세척하고, 의심스러운 부분이 있다면 섭취하지 않는 것이 안전합니다.

안전한 산나물 섭취를 위한 당부
영양군 관계자는 주민들에게 산나물 섭취에 각별한 주의를 당부했습니다. 이번 사고를 계기로 산나물 채취 및 섭취에 대한 경각심을 높이고, 안전한 먹거리 문화를 조성하는 것이 중요합니다. 출처가 불분명한 산나물은 피하고, 의심스러운 증상이 나타나면 즉시 의료기관을 방문해야 합니다.

산나물 식중독, '이것'만은 꼭 기억하세요!
산나물 라면으로 인한 식중독 사고는 식용 가능한 나물이라도 이물질 혼입 가능성이 있음을 보여줍니다. 안전한 산나물 섭취를 위해서는 반드시 출처를 확인하고, 의심스러울 때는 섭취를 피하는 것이 최선입니다. 건강을 위해 먹는 산나물이 오히려 독이 되지 않도록 주의가 필요합니다.

산나물 식중독, 궁금하신 점들
Q.식중독 증상은 어떻게 나타나나요?
A.식중독 증상은 섭취한 독성 물질의 종류에 따라 다르지만, 일반적으로 구토, 설사, 복통, 어지럼증, 마비 증상 등이 나타날 수 있습니다.
Q.전호나물은 원래 식용 가능한 나물인가요?
A.네, 전호나물은 울릉도 등지에서 식용으로 사용되는 나물이 맞습니다. 하지만 이번 사고는 다른 물질이 혼입되었을 가능성에 무게를 두고 조사 중입니다.
Q.산나물 섭취 시 가장 주의해야 할 점은 무엇인가요?
A.가장 중요한 것은 섭취하는 산나물이 식용 가능한 종류인지, 그리고 독초나 유해 물질이 섞여 있지 않은지 확인하는 것입니다. 출처가 불분명한 산나물은 피하는 것이 좋습니다.

'이슈' 카테고리의 다른 글
| 헬륨 대란 경고! 한국 반도체, '취약 국가' 오명 벗을 수 있을까? (0) | 2026.04.01 |
|---|---|
| 출근길 악몽: 10m 아래 논으로 추락한 통근버스, 25명 전원 부상 (0) | 2026.04.01 |
| 세 살배기 천사의 따뜻한 용기: 외로운 노인에게 건넨 '함께 식사할래요?' (0) | 2026.04.01 |
| 다주택자 대출 숨통 조인다! 26년 가계부채 관리방안 핵심 총정리 (0) | 2026.04.01 |
| 코스피 급등! 매수 사이드카 발동… 투자자들 환호성 (0) | 2026.04.01 |